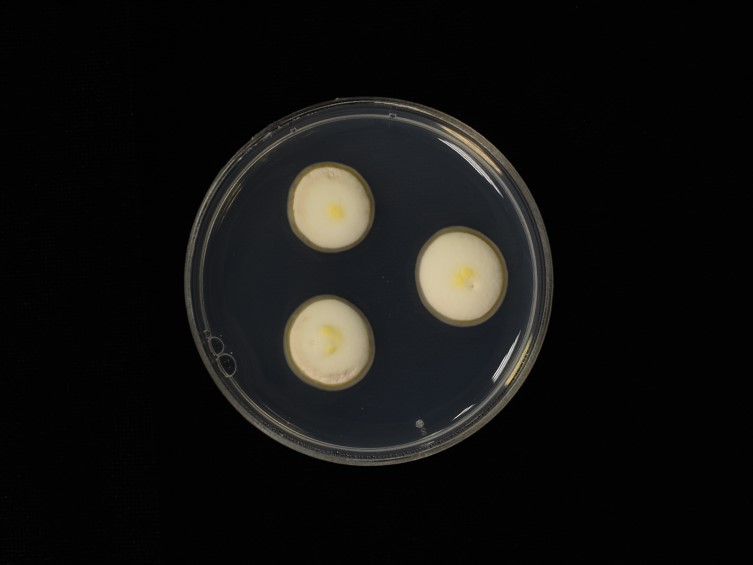

Holotype:
THAILAND, Nakhon Ratchasima Province, Khao Yai National Park, 9 Aug. 2016, A. Khonsanit, D. Thanakitpipattana, K. Tasanathai, P. Srikitikulchai, R. Somnuk, S. Mongkolsamrit, W. Noisripoom, holotype BBH 43217, ex-type living culture BCC 82984.
Habitat:
Leaf litter, Buried in the soil.
Host:
Adult worker of Polyrhachis sp.
Description:
 Stroma arising from between the head and pronotum of adult worker of Polyrhachis sp., simple, solitary, yellow to yellow orange, orange, 5-9.5 cm long. Fertile head sterminal, globose, ellipsoid, ovoid with papillate apices, yellow orange; ostioles slightly protruding on the surface of the ascomata, 1.5-3 × 1.8-2 mm.
Stroma arising from between the head and pronotum of adult worker of Polyrhachis sp., simple, solitary, yellow to yellow orange, orange, 5-9.5 cm long. Fertile head sterminal, globose, ellipsoid, ovoid with papillate apices, yellow orange; ostioles slightly protruding on the surface of the ascomata, 1.5-3 × 1.8-2 mm.  Perithecia obliquely immersed, obclavate, obpyriform, elongate flask-shaped, 600-750 × 190-280 μm.
Perithecia obliquely immersed, obclavate, obpyriform, elongate flask-shaped, 600-750 × 190-280 μm.  Asci hyaline, cylindrical, capitate, 443-638 × 5-9 μm. Asci-caps rounded, 5-8 × 7-10 μm.
Asci hyaline, cylindrical, capitate, 443-638 × 5-9 μm. Asci-caps rounded, 5-8 × 7-10 μm.  Ascospores hyaline, filiform, multi-septate and breaking into 64 part-spores, 400-538 × 1-2 μm. Part-spores hyaline, barrel-shaped, allantoid, cylindrical with truncated apices, 5-19 × 1-2 μm.
Ascospores hyaline, filiform, multi-septate and breaking into 64 part-spores, 400-538 × 1-2 μm. Part-spores hyaline, barrel-shaped, allantoid, cylindrical with truncated apices, 5-19 × 1-2 μm.
Culture characteristics:
Colonies growing on PDA slowly, ca 13 mm diam after ca 8 wk at 25 °C, at first white turning to pale-yellow, slightly convex, dense aerial hyphae, synnemata produced after ca 4 wk, pale-yellowto yellow and becoming yellow-orange at the top with white
Colonies growing on PDA slowly, ca 13 mm diam after ca 8 wk at 25 °C, at first white turning to pale-yellow, slightly convex, dense aerial hyphae, synnemata produced after ca 4 wk, pale-yellowto yellow and becoming yellow-orange at the top with white  conidia after ca 6 wk.
conidia after ca 6 wk.  Conidiogenous cells (phialides) clavate, obclavate, denticled, stout and protuberant, 5–16 × 3–6 μm with oil globules as orange pigments. Conidia single cells, smooth-walled, pigmented, solitary, obovoid, fusiformelliptical, 3–11 × 1–2.5 μm. The reverse side of the colonies is brown to dark brown.
Conidiogenous cells (phialides) clavate, obclavate, denticled, stout and protuberant, 5–16 × 3–6 μm with oil globules as orange pigments. Conidia single cells, smooth-walled, pigmented, solitary, obovoid, fusiformelliptical, 3–11 × 1–2.5 μm. The reverse side of the colonies is brown to dark brown.
Reference:
Khonsanit A, Luangsa-ard JJ, Thanakitpipattana D, et al. (2019). Cryptic species within Ophiocordyceps myrmecophila complex on formicine ants from Thailand. Mycological Progress 18: 147–161.
DOI: https://doi.org/10.1007/s11557-018-1412-7Species |
Strain |
Compound |
Pubchem CID |
Biological activity |
Reference |
|---|
|
Strain |
|---|